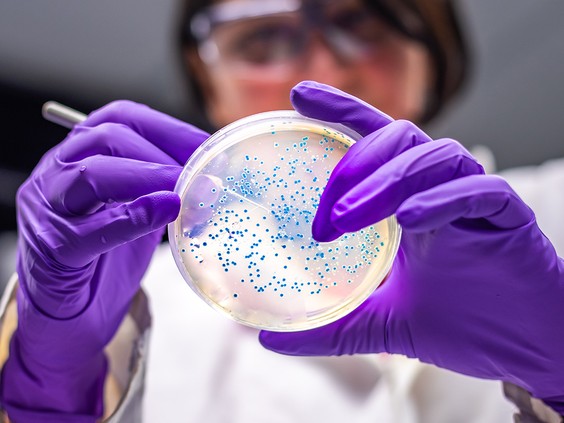
https://smartcdn.gprod.postmedia.digital/nationalpost/wp-content/uploads/2025/09/Title.jpg?quality=90&strip=all&w=564&h=423&type=webp&sig=liyyxxPOxwxLmqJDc_FmBw

Super Pathogens "Armed to the Teeth"
"[The pathogen watchlist] reflects the current reality in Canada.""[Carbapenems are powerful antibiotics] -- the last station on the penicillin highway. If you look at your IV bag and you see the word carbapenem, you know you're in trouble.""It's not something that's given all the time, and resistance to that class of drugs has spread like wildfire over the last 20 years or so.""[Carbapenem0resistant Pseudomonas -- another[ super-bad bug [was also ranked high priority].""It's a vicious organism, really intrinsically drug-resistant. It doesn't seem to care too much about any antibiotics. It's very well armed to the teeth and causes all sorts of things like pneumonia."Dr. Gerry Wright, professor of biochemistry and biomedical sciences, McMaster University, Hamilton"If you can't treat gonorrhea, it can lead to pelvic inflammatory disease or infertility in the future.""And no matter what drug you bring into the country, resistance is inevitable."Dr. Kanchana Amaratunga, medical adviser, antimicrobial resistance task force, Canada
|
Dr. Wright's lab isolated a protein from a bacterium taken from a soil sample. "It has activity against almost all of the pathogens that we care about on that list" on lab mice, he said. Referencing the newly updated list of pathogens federal health officials highlight as posing threats to Canadians. Dr. Wright's work related to the bacterium was published in the journal Nature recently. He and his staff have been attempting to refine the bacterium's development to make it a candidate for a new drug.
Virtually all instances of invasive pneumococcal disease which rose by 82 percent from 2021 to 2022 in Canada, are caused by vaccine-preventable strains.
The Canadian medical community faces a steady epidemic in the occurrence of antibiotic-resistant pathogens, some of which have developed to withstand any drug thought to have been capable of inoculating against their vicious depredations on the human body, like a fungus that boasts a rate of death up to 60 percent. Such medical threats are listed on a newly-released "high impact" superbug list that includes a family of bacteria that causes E.coli and salmonella, as well as a drug-resistant gonorrhea.
There are fewer pathogens listed now, by fifty percent flagged by Public Health Agency of Canada expert working and advisory groups, totalling 28. But those selected for inclusion were scored and ranked based on treatability, transmission, case fatality ratio -- equal to the proportion of confirmed fatal cases -- and effects on marginalized communities such as Indigenous; the drug-addicted, gay, bisexual, homeless, new immigrants and refugees entering the country from regions of the world where conflict and disaster reign.
New emerging threats include Candida auris, a fungus that is drug-resistant and which spreads in hospitals, capable of causing infections of the blood, heart, nervous system and organs -- and Mycoplasma genitalium, an infection that is sexually transmitted. Infectious bugs that are already familiar include Streptococcus pneumoniae that can lead to life-threatening meningitis, pneumonia or sepsis -- with children and the elderly at greatest risk -- are now increasingly drug-resistant.
 |
| Meningitis-causing fungus Exserohilum rostratum. Changes in the microbiome may allow another fungal species, Candida auris, to further emerge. (Pouya Dianat/The Associated Press) |
"Things are going to get to the point that we're going to be seeing a lot more people staying in hospital or even dying, because the antibiotics are not working", warns Dr. Wright, concerned that no new drugs are entering the market. Needless to say, it is not only Canada that faces these threats; antimicrobial resistance is a global health threat that occurs when infections caused by bacteria, viruses, fungi and parasites cannot be countered by antibiotics, antivirals and drugs designed to kill them.
High priority pathogens that rank top of the four tiers in Canada's 'pathogen prioritization list' includes carbapenem-resistant Enterobacterales, a family of bacteria normally present in the human gut that can cause infections; the group that includes E.coli and salmonella can cause urinary tract, abdominal and bloodstream infections. Spread person-to-person, through contact with soiled hands, wounds, stool or contaminated medical equipment and devices.
Canada's national gonorrhea rate in 2022 was three times the prevalence three decades earlier; the highest in 30 years Rates are steepest in men aged 20 to 39, and women 15 to 30, spreading readily, associated with travel-related sexual contact, and the risk of HIV increases as well. The McMaster lab where Dr. Wright is hard at work proposing to succeed in killing Pseudomonas "Because if you've got something that will kill Pseudomonas, it will probably kill everything else", holds hope in eventual success.
| A medical illustration of Candida auris fungal organisms |
According to the task force, the fungus has "now emerged as a critical public health threat" due to its resistance to multiple antifungals, high morbidity and the ease with which it can spread in healthcare settings. Both Drs. Wright and Amaratunga emphasize the need for prevention; judicious and appropriate use of antibiotics, beefed up surveillance, early detection and vaccines.
Hospital: an institution providing medical and surgical treatment and nursing care for sick or injured people. Additionally now, a place where infectious diseases and pathogens that can be life-threatening can spread and infect patients. Patients who arrive at hospitals generally as a final resort for treatment of chronic or temporarily-acquired health challenges, or visiting as a result of injuries...all of whom whatever the reason for hospitalization, trust that their medical conditions will be ameliorated with medical care leading to discharge and resumption of normal life.
"[Microbes can evolve rapidly, within hours. However, unlike the heydays of the 1980s], It's now a completely different kettle of fish. There are very few drug companies working in the field.""They can't make money on it. Antibiotics cure disease. If you're a large pharma company, you like to be controlling chronic diseases, because then people take your drugs for a very long time [a guaranteed revenue stream]."Dr. Gerry Wright

Labels: "High Impact" Superbugs, Antibiotics, Disease Prevention, Drug-Resistant Pathogens, Infectious Bacteria

0 Comments:
Post a Comment
<< Home